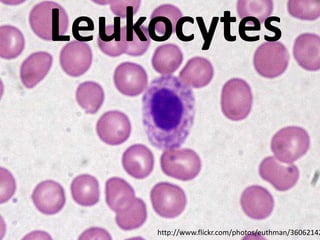
Leukocytes


    http://www.flickr.com/photos/euthman/36062142

This document contains a list of medical terms and their associated Flickr image URLs. The terms include fungi, malaria, virus, vaccine, antibiotics, leukocytes, antigen, protozoa, bacteria, and chicken pox. Each term has a Flickr URL link provided presumably showing a relevant image for that medical concept.